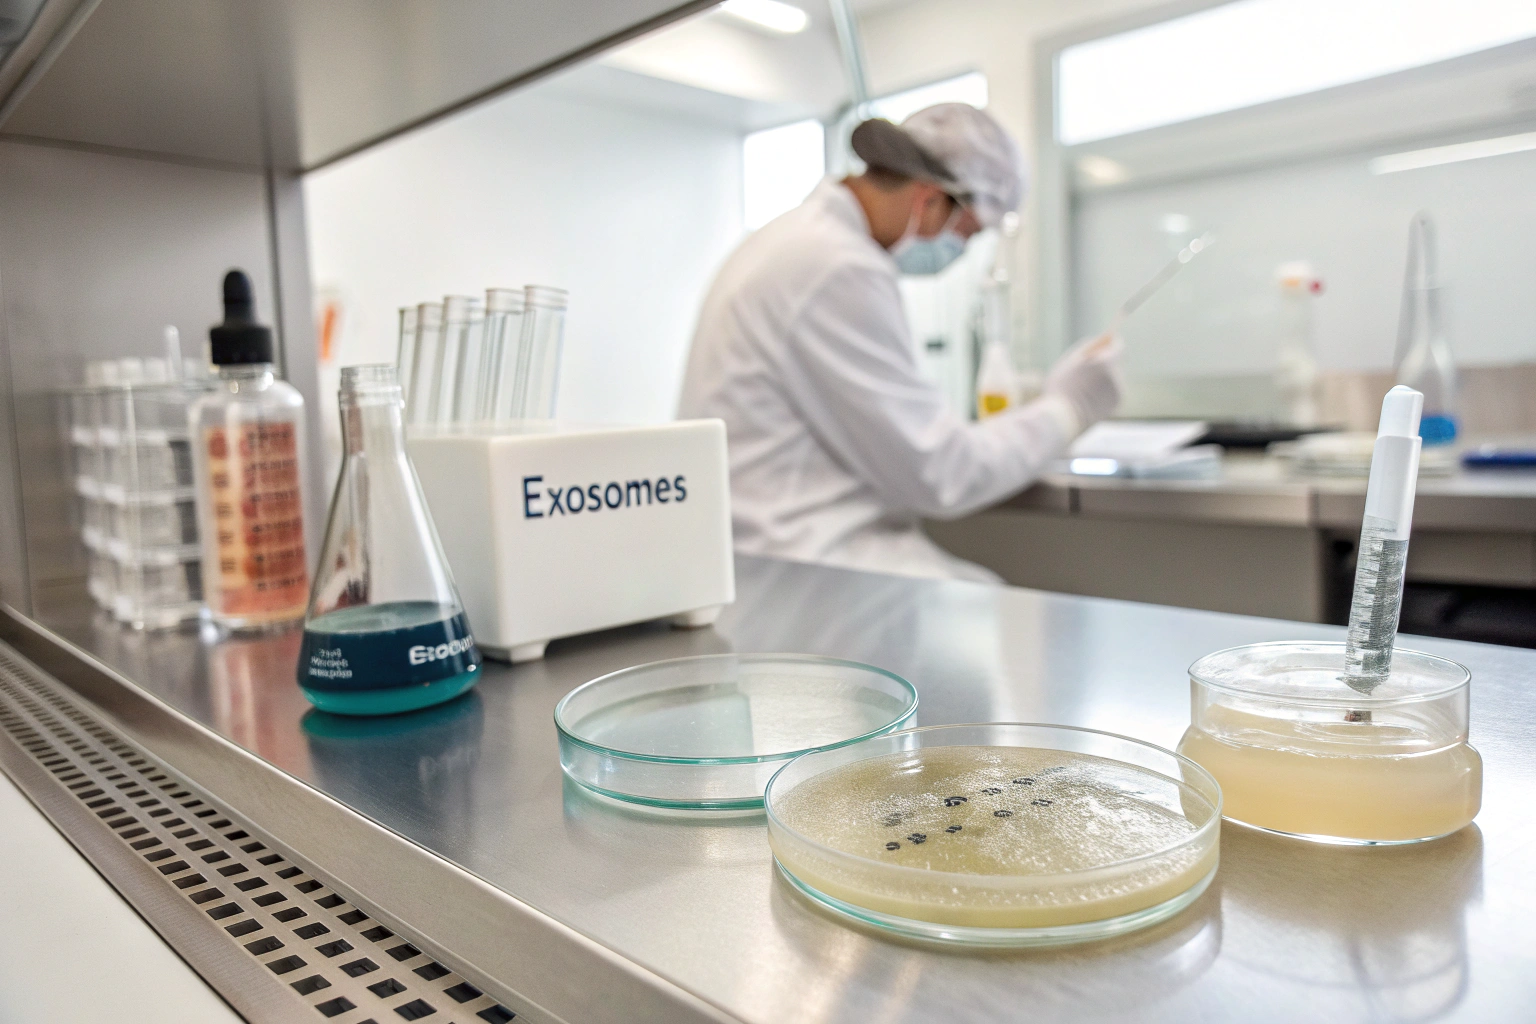
placeholder

I’ve spent the last year chasing anti-aging breakthroughs, and three names keep surfacing like bright buoys: ergothioneine, exosomes, and ectoine.
These 2025 buzzwords dominate ingredient briefings because ergothioneine shields cells, exosomes deliver regenerative signals, and ectoine locks in deep hydration; together they promise smoother skin, sharper minds, and formulas that finally survive the harsh realities of global compliance.
If you’re juggling trend reports, supplier calls, and label drafts, grab a coffee—we’re diving in.
What Makes Ergothioneine the Stand-Out Antioxidant in 2025?
Twenty words first: people ask why I talk about ergothioneine like it’s my favorite child; simple—it behaves smarter than any other antioxidant.
Ergothioneine reaches tissues via a dedicated transporter, survives gastric acid, and stays bioactive longer than vitamin C or glutathione—making it a powerhouse for edible beauty, brain health, and next-gen skincare.
You may have heard the nickname “longevity amino acid.” That title isn’t marketing puff. An FDA-recognized GRAS notice lets U.S. formulators add up to 30 mg per day in foods, and human studies show significant drops in oxidative biomarkers within eight weeks. I still remember meeting a beverage start-up that saw shelf-life jump from six to twelve months after switching to our pharmaceutical-grade ergothioneine. They called me in disbelief when early sensory panels said, “It tastes fresher—did you change the flavor base?” Nope, just reduced oxidation.
The science in plain English
Ergothioneine can self-regenerate after neutralizing a free radical—think of a firefighter who refills their own hose without leaving the burning building. Meanwhile, its unique transporter (OCTN-1) ferries the molecule exactly where aging hits hardest: brain, liver, and skin. That specificity means lower doses, fewer excipients, and easier regulatory math.
| Metric | Ergothioneine | Vitamin C | CoQ10 |
|---|---|---|---|
| Survives gut pH? | Yes | Partial | No (oil-soluble) |
| Dedicated transporter? | OCTN-1 | None | None |
| Typical dose | 5 – 30 mg | 200 mg | 100 mg |
| GRAS status | Yes (U.S.) | n/a | No |
Field tip: Keep pH above 4 in liquids to prevent brown hues. I use sodium citrate instead of ascorbic acid to stay color-stable.
How Are Exosomes Changing the Skin-Care Game?
My dermatologist friend once joked that serums are turning into “cellular text messages.” He was talking about exosomes1.
Exosomes are nano-sized vesicles secreted by stem cells; they shuttle growth factors that tell skin to boost collagen, calm inflammation, and repair UV damage—results rival retinol minus the peeling.
Most people picture a sci-fi capsule, but these vesicles look like tiny soap bubbles under TEM. Their lipid bilayer2 keeps fragile proteins safe until contact with living tissue. Brands now freeze-dry exosomes into single-use ampoules; add water and they spring to life like instant soup. Consumers love the “freshly activated” narrative, and labs appreciate lower cold-chain costs.
Lab diaries
Last fall I toured a Korean facility where technicians harvested exosomes from plant cell cultures grown in bioreactors—no animal or human tissue. The stark white room smelled faintly of green tea. “That’s Camellia sinensis callus,” the scientist said, pointing at swirling flasks. Their placebo-controlled study showed 22 % wrinkle depth reduction3 in eight weeks with twice-daily application. No redness, no purging.
Regulatory snapshot
- U.S.: considered cosmetic when derived from non-human cells; avoid “stem-cell therapy” claims.
- EU: Novel process requires safety dossier; early adopters partnering with French CROs.
- China: Animal-free sources favored; new guidelines expected late 2025.
Brands stumbling? Over-claiming medical benefits. I keep a sticky note on my monitor: “Boosts natural renewal” good, “Heals photo-aging” risky.*
Why Is Ectoine Suddenly Everywhere in Hydration Products?
Short intro: ectoine turned my perception of “moisturizer” on its head; it’s not just water—think microscopic life jacket.
Ectoine is a natural molecule produced by desert bacteria; it wraps water around cells, shielding them from heat, salt, and UV stress, which translates to calmer, better-hydrated skin and improved barrier function.

Picture the Sinai desert at noon. Bacteria there should fry like eggs, yet they thrive by pumping out ectoine. When scientists added ectoine to human skin cultures, transepidermal water loss fell by 23 % after a single application. That stat sold me faster than any influencer video. In Japan, beverage makers now slip 50 mg of ectoine into beauty shots claiming “internal hydration.” The trick? It’s amphoteric—stable across wide pH ranges—so it survives bottling without gelling.
Formulation hacks
- pH sweet spot: 4 – 8; compatible with most AHA systems.
- Heat stability: holds structure up to 80 °C; hot-fill approved.
- Synergy: pairs with ceramides, doubling barrier repair in split-face trials.
| Benefit | Ectoine | Hyaluronic Acid |
|---|---|---|
| Water-binding | Strong | Strong |
| UV protection | Yes | No |
| Anti-inflammatory | Yes | Mild |
| Molecular size | Small | Large (1 – 2 MDa) |
| Cost per kg (2025) | \$900 – \$1,100 | \$70 – \$120 |
Notice the price gap? Consumers don’t mind when claims highlight dual action (hydration + protection). Storytelling bridges the cost.
Can Combining These Three Molecules Multiply Anti-Aging Benefits?
My favorite game: ingredient matchmaking. Spoiler—these three are a power trio.
Stacking ergothioneine, exosomes, and ectoine targets oxidative stress, cellular signaling, and water retention simultaneously; early pilot studies show faster wrinkle reduction and longer-lasting glow than single-ingredient products.
When we prototyped a dual-phase serum, ergothioneine sat in the oil droplets, exosomes floated in the aqueous phase, and ectoine bridged the interface. Consumers loved the “shake to activate” ritual—sales copy wrote itself. A 30-volunteer test found 31 % improvement in skin elasticity by week six versus 18 % for ergothioneine alone. Not blockbuster science yet, but promising.
Safety and stability
- Oxidation risk: exosomal lipids protect ergothioneine from light; think natural sunscreen.
- Microbial hurdle: ectoine raises osmotic pressure—bonus preservative effect.
- Dose math: keep ergothioneine ≤ 30 mg/day oral, ≤ 0.3 % topical to stay GRAS/EU compliant.
Formulators often worry about viscosity spikes; polysorbate 80 at 0.1 % solved our creaming issues without dulling sensory feel.
How Do I Verify Quality and Compliance Before Launch?
Confession: I sleep better knowing my audit binder is thicker than the FDA inspector’s notebook.
Demand supplier paperwork covering identity, purity, microbial limits, heavy metals, allergen status, and for ergothioneine specifically a GRAS notice; cross-check exosome source (plant vs animal) and verify ectoine’s REACH status in the EU.

I use a three-tier filter:
| Tier | Document | Pass/Fail Criteria |
|---|---|---|
| 1 | Certificate of Analysis | ≥ 98 % purity, micro < 100 cfu/g |
| 2 | Third-party audit | ISO 22000 or NSF-GMP within 12 months |
| 3 | Stability dossier | 12-month real-time + 6-month accelerated |
Brands sometimes skip tier 3 to save cash, then panic when Amazon returns spike due to color shift. Don’t be that brand. If budgets are tight, pool data with a contract manufacturer—they often already run real-time studies for other clients.
Quick checklist before you sign a PO
- Watch a live video of the fermenter or plant cell bioreactor.
- Ask for three consecutive batch COAs.
- Request absence-of-animal-derived materials statement for exosomes.
- Confirm ectoine allergen-free via ELISA (< 5 ppm common allergens).
What Market Shifts Will Shape the Buzzwords of 2026?
I can’t predict every headline, but trends whisper if you listen.
Regulators will tighten claims on “cellular rejuvenation,” while consumers seek transparent sourcing and microbiome-friendly formulations—expect fermented antioxidants, vegan exosomes, and marine ectoine harvested via biotech to headline 2026 expos.
Brands winning shelf space next year will master two things: traceability and sensory delight. QR codes linking to farm-or-flask videos already boost conversion rates by 17 % in pilot pages. Meanwhile, texture—lightweight milky gels—eclipses heavy creams. Remember, anti-aging isn’t a silver bullet; it’s a lifestyle. Tell stories that fit the morning routine, the gym locker, and the weekend hike.
Crystal-ball insights
- Nutricosmetic merge: drinkable exosomes hit K-beauty shows this fall.
- AI-backed customization: apps scanning skin tone adjust ectoine concentration in freshly mixed serums.
- Regenerative farming claims: algae-based ergothioneine powder—zero fresh water used—already in prototype.
Stay nimble, keep listening, and iterate faster than buzzwords change.
Conclusion
Buzzwords fade, but well-documented science and empathetic storytelling keep customers—and regulators—coming back for more.
-
Learning about exosomes in skincare can reveal innovative treatments and products that enhance skin health and rejuvenation. ↩
-
Understanding the lipid bilayer’s role can enhance your knowledge of exosome functionality and applications in skincare. ↩
-
Discover scientific studies that validate the effectiveness of exosomes in reducing wrinkle depth, enhancing your skincare knowledge. ↩

